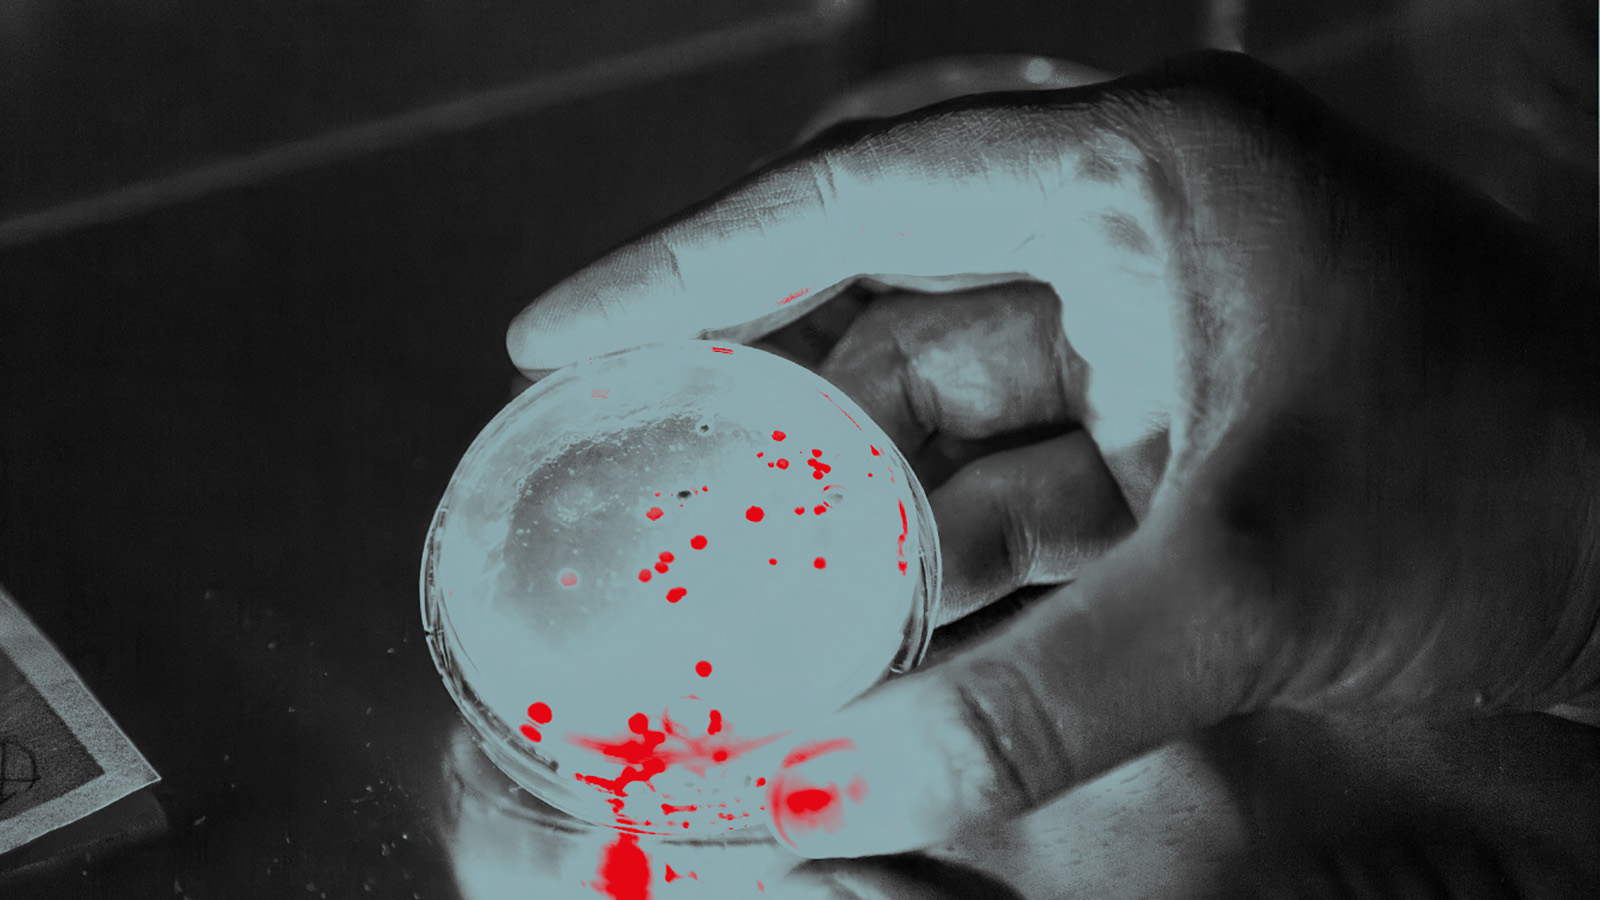
självlysande bakterier

Där vetenskap och konst möts
The Cell är en plats där forskning, konst och filosofi förenas i nya former. Genom utställningar, interaktiva upplevelser och samtal utforskar vi livets stora frågor och utmanar sättet vi ser på världen. Här möts kreativitet och vetenskap för att skapa nya perspektiv och insikter. Vi skapar en dynamisk miljö där gränser suddas ut.